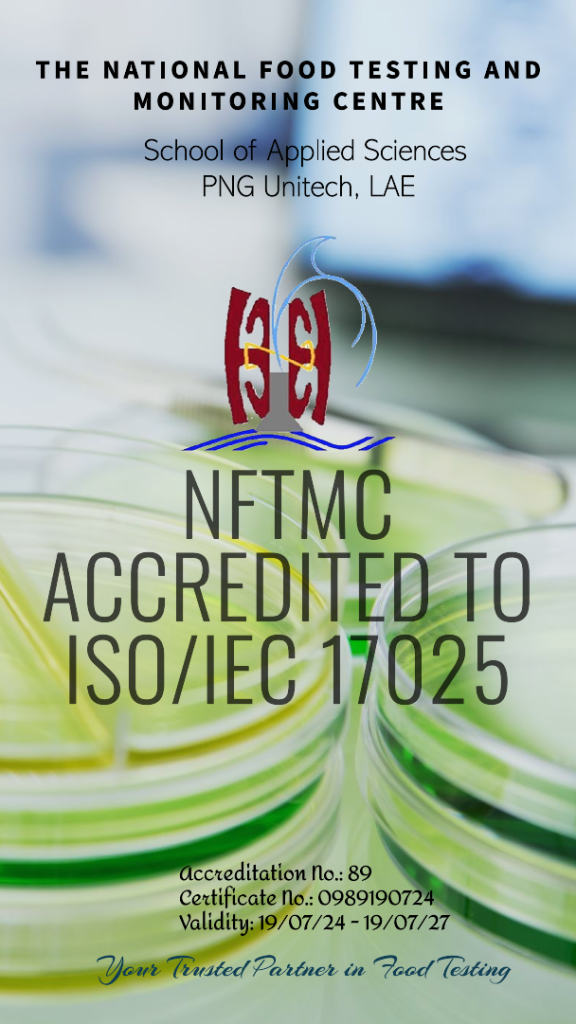

National Food Testing and Monitoring Centre (NFTMC)
Welcome
Welcome to the National Food Testing and Monitoring Centre!
NFTMC
The National Food Testing and Monitoring Centre (NFTMC) is located at the School of Applied Sciences, PNG University of Technology’s Taraka Campus in Lae, Morobe Province. The university’s School of Applied Sciences provides laboratory facilities and academic resources to support NFTMC’s work.
Campus News/Updates
Find out what's happening on campus

